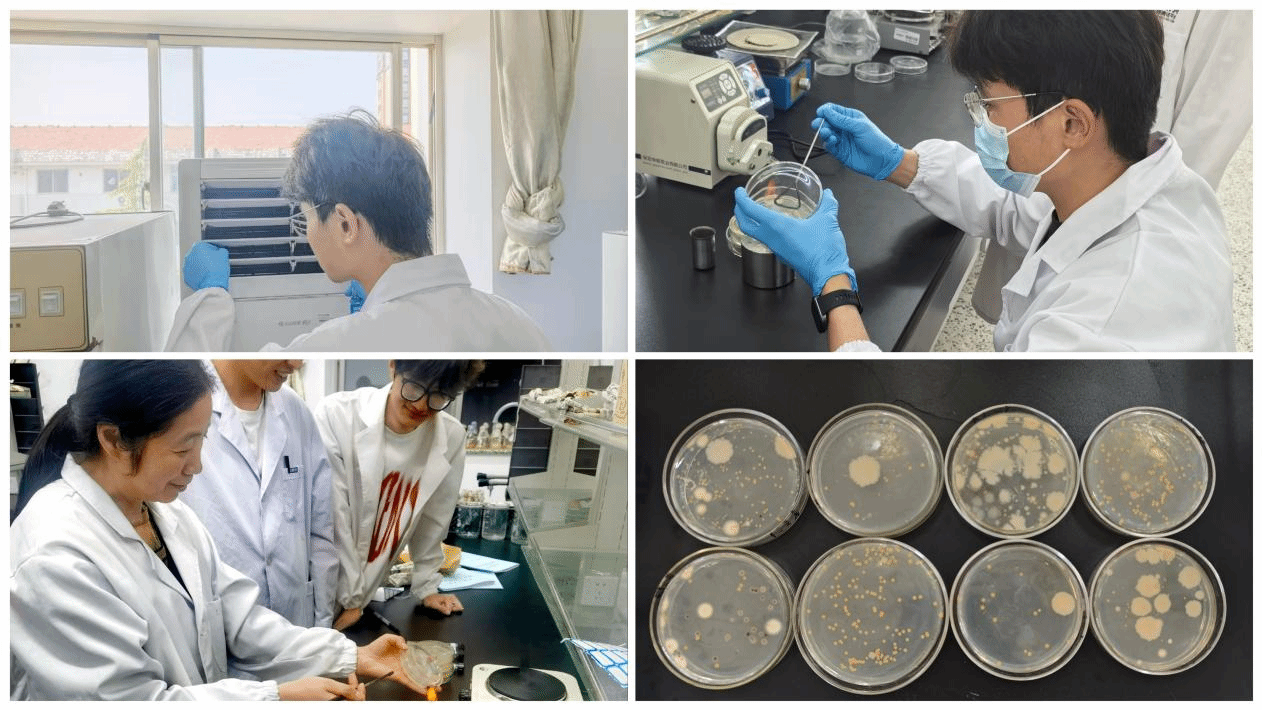

在五一劳动节来临之际,为弘扬劳动精神,营造整洁文明的寝室环境,4月27日,英国上市公司365联合“海梦启航”一站式社区开展了“从‘芯’开始,全‘室’焕新”主题卫生文明寝室评比系列活动之一全院空调大清洗。英国上市公司365党总支书记高留才、学工办主任郭海松、院团委书记王晶晶、10余名党员代表及67名志愿者共同参与,以实际行动发挥党员先锋模范作用。
活动开始前一周,生物系李朝霞教授带领B生物212查志伟、韩龙珺、田佳欣等员工使用无菌采样拭子,分别对男女生宿舍及实验室空调滤网、蒸发器等关键部位进行微生物样本采集,并把微生物在培养基上培养。实验结果发现除了大量颗粒污染物外,细菌总数都在10的4次方及以上,说明无论宿舍还是实验室均存大量超过清洁空气标准的微生物。李朝霞教授建议空调应该定期清洗,这样才能提升空气质量、延长空调寿命、预防疾病,守护老员工的健康。
活动当天中午1:00,志愿者们在10号楼前集中,分发劳动用品。高留才发现大部分同学不会操作。他结合生活实际,向同学们讲解空调滤网的清洁方法,并贴心提醒:“近期天气多变,使用空调要适度,避免贪凉影响健康。”他强调,此次活动不仅是志愿服务,更是一堂生动的劳动教育课。“大家在擦拭灰尘的同时,也在传递彼此间的关怀,培养责任与担当。”随后分成27支小分队正式开启男女生宿舍、实验室空调清洗行动。
活动中,志愿者们两人一组,礼貌敲门询问,耐心讲解操作规范:“先断电,再清洗,安全第一!”他们细心拆下滤网,冲洗积灰,擦拭晾干,最后精准安装。“原来空调滤网要这样清洗!”围观的宿舍同学掏出手机记录操作要点。志愿者们边操作边讲解,将劳动技能传授给更多同学。
实验室空调台式比较多,台式空调可比挂式空调难洗多了,光拆空调就费了好大力气。台式空调的滤网也比较大,清洗比较麻烦,但是,只要功夫深铁杵磨成针,缓慢的流水搭配着一丝不苟的清洗,实验室的空调也算是焕然一新了。
第一次参加此次洗空调活动的志愿者B食品242姚书妍同学表示,清洗空调部件,看着堆积的灰尘被清理,真切感受到清洁对生活环境的重要性。与同学协作时,不仅提升了动手能力,更体会到团队力量。看到宿舍中空调焕然一新,听到他们的感谢,内心满是成就感。这次活动让我明白,小事也能传递温暖,用实际行动服务他人,就是青春最有意义的注脚。
参加劳动的B生物232 钱浩同学也突然明白:每一份劳动都有属于它的价值与意义。亲自体验了洗空调这一简单劳动,让我看见生活中最质朴的环保哲学——养护即关怀,洁净即温度。
此次活动历时三天,志愿者同学为全院223间寝室及4个实验室提供了空调清洁服务,他们用实际行动诠释了"劳动最光荣"的真谛,也为建设文明寝室树立了标杆。
样本采集培养

简短动员

男女宿舍、宿管值班室清洗

实验室清洗

部分党员和积极分子合影